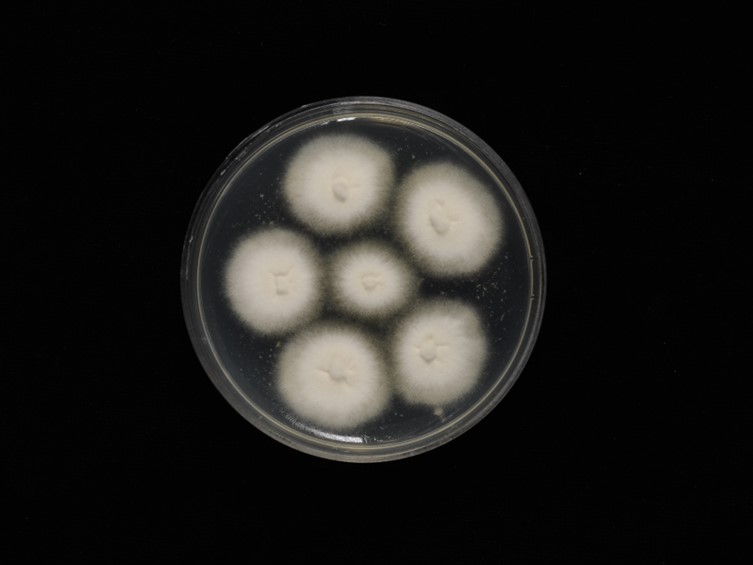

Holotype:
THAILAND, Nakhon Ratchasima Province, Khao Yai National Park, 1 Nov. 2016, D. Thanakitpipattana, N. Kobmoo, R. Somnuk & B. Sakolrak, holotype BBH 42322, ex-type living culture BCC 83025.
Habitat:
Underside of a dicotyledonous leaf
Host:
Ophiocordyceps dipterigena
Description:
 Host covered by dense, white and cottony mycelium forming on the stromata of Ophiocordyceps dipterigena s.l.Hyphae septate, hyaline, smooth walled, irregularly branched, 1–2 µm wide. Conidiophores mono or synnematous, septate, cylindrical, simple, dichotomously or irregularly branched of variable length.
Host covered by dense, white and cottony mycelium forming on the stromata of Ophiocordyceps dipterigena s.l.Hyphae septate, hyaline, smooth walled, irregularly branched, 1–2 µm wide. Conidiophores mono or synnematous, septate, cylindrical, simple, dichotomously or irregularly branched of variable length.  Conidiogenous cells arising directly from the hyphae, cylindrical, 12–60 × 1–2 µm, bearing a rather irregularly, geniculate rachis.
Conidiogenous cells arising directly from the hyphae, cylindrical, 12–60 × 1–2 µm, bearing a rather irregularly, geniculate rachis.  Conidia forming singly on denticles, cylindrical with rounded ends and on apiculus, hyaline, smooth-walled, aseptate, 5–10 × 1–2 µm.
Conidia forming singly on denticles, cylindrical with rounded ends and on apiculus, hyaline, smooth-walled, aseptate, 5–10 × 1–2 µm.
Culture characteristics:
Colonies on PDA attaining a diam of 13–15 mm in 20 d at 25 °C, cottony, pale
yellow.
Colonies on PDA attaining a diam of 13–15 mm in 20 d at 25 °C, cottony, pale
yellow.
Reference:
N. Kobmoo, K. Tasanathai, J.P.M. Araújo, et al. (2023). New mycoparasitic species in the genera Niveomyces and Pseudoniveomyces gen. nov. (Hypocreales: Cordycipitaceae), with sporothrix-like asexual morphs, from Thailand . FUSE12: 91–110.
DOI: http://doi.org/10.3114/fuse.2023.12.07Species |
Strain |
Compound |
Pubchem CID |
Biological activity |
Reference |
|---|
|
Strain |
|---|
| BCC 73628 |
| BCC 74477 |
| BCC 83025 |